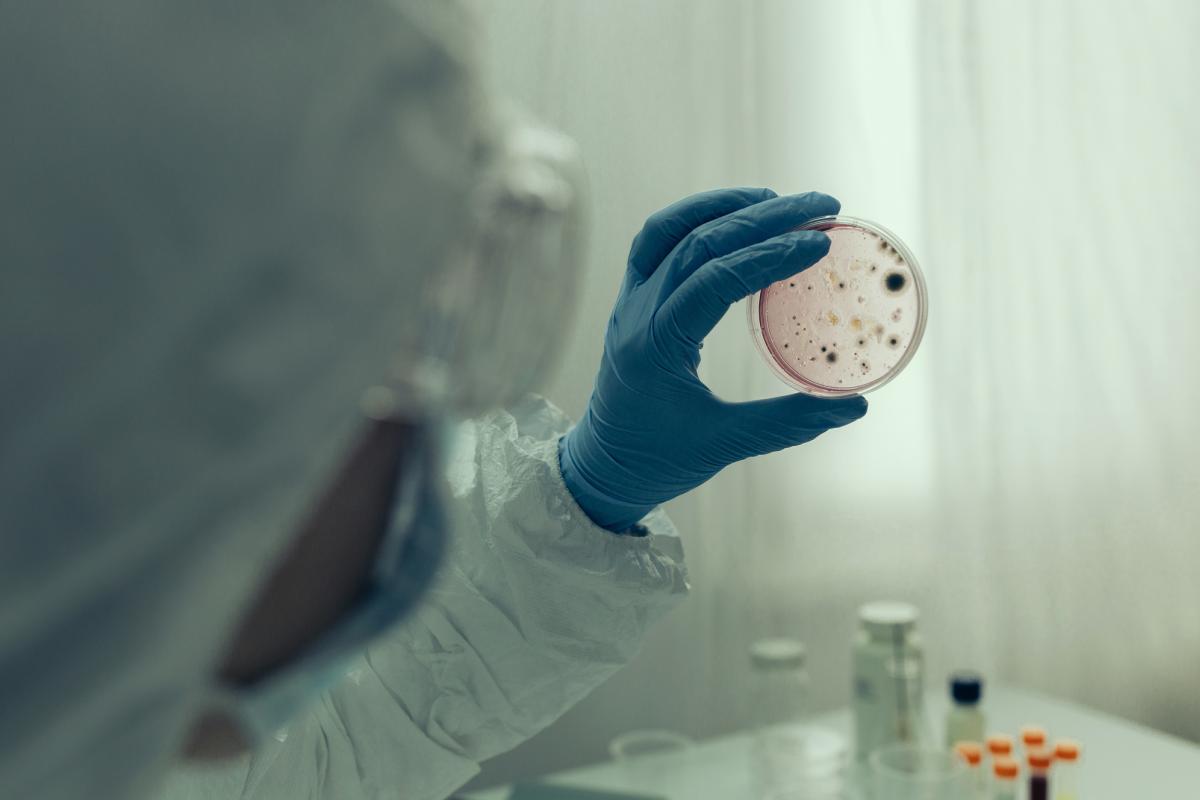

Se crean seis laboratorios para enfrentarse a la "enfermedad X"
Durante los próximos siete años serán financiados en el marco del programa EU4Health.
La Comisión Europea intenta proteger a la población de seis categorías de enfermedades conocidas y desconocidas que se espera que surjan durante al menos los próximos siete años. Así afronta la comunidad mundial de enfermedades infecciosas la espera ante la infección desconocida que traerá la próxima pandemia: la "enfermedad X".
Para ello, se están creando seis laboratorios de referencia para la salud pública en el territorio de la Unión Europea, que durante los próximos siete años serán financiados en el marco del programa EU4Health, según ha informado el medio griego In science.
Estos laboratorios intentarán ofrecer una solución a las graves amenazas transfronterizas para la salud tras los conocimientos adquiridos en la pandemia por el covid-19. Recogerán sus conocimientos científicos especializados y los transmitirán a los Estados miembros de toda la Unión Europea, con el fin de mejorar la preparación, la detección precoz y la preparación de la respuesta de Europa a las infecciones de alto riesgo.
Los laboratorios cubrirán las siguientes áreas: infecciones con bacterias resistentes a los antibióticos, virus patógenos transmitidos por insectos y animales, virus patógenos emergentes de origen roedor y zoonosis, nuevas bacterias emergentes de alto riesgo procedentes de zoonosis, legionella y difteria y tos ferina.
Los seis laboratorios europeos de referencia, liderados por El Centro Europeo para la Prevención y Control de Enfermedade (ECDC), apoyarán a los laboratorios nacionales de salud pública garantizando la comparabilidad de los datos y reforzando la capacidad en métodos de laboratorio a nivel de la UE. Esto incluye esfuerzos para coordinar el diagnóstico y el uso de pruebas diagnósticas, de modo que es posible monitorear, notificar y reportar enfermedades.
Los laboratorios
El primer laboratorio, en Copenhague, Dinamarca, se dedica a la resistencia a los antimicrobianos con sede en el Statens Serum Institute, en colaboración con la Universidad Técnica de Dinamarca, el Departamento de Microbiología Clínica de la Universidad de Copenhague en el distrito de Kronoberg y el Centro de Microbiología de Växje. Hospital Central, Suecia.
El segundo laboratorio, con sede en el Instituto Rijks de Bilthoven, Países Bajos, se ocupa de los virus transmitidos por vectores (insectos, animales). En este taller también participan el Instituto Nacional Francés de Investigación Médica y de Salud de París, la Universidad Aristóteles de Tesalónica, la Universidad de Padua en Italia y la Universidad de Ljubljana en Eslovenia
El tercero es un consorcio liderado por el Servicio de Salud Pública del Instituto Karolinska, Suecia, en colaboración con el Instituto Nacional de Enfermedades Infecciosas Lazzaro Spallanzani de Italia en Roma, el Instituto Pasteur de Francia en París y el Centro Nacional de Salud Pública de Hungría en Budapest. Las responsabilidades de esta oficina son los virus emergentes de roedores y las zoonosis.
El cuarto laboratorio trata las bacterias emergentes de alto riesgo derivadas de zoonosis. Se trata de un consorcio liderado por el Instituto Robert Koch de Berlín, el Instituto de Microbiología del Ejército Alemán en Munich, el Servicio de Salud Pública de Suecia y el Instituto Nacional de Salud de Portugal Dr. Ricardo Jorge en Lisboa.
El quinto laboratorio trata sobre legionella. Es un consorcio liderado por el Hospital Universitario de Lyon, Francia, en el que participan el Instituto Nacional de Salud de Italia en Roma, la Universidad Técnica de Dresde en Alemania y el Instituto Nacional de Salud Dr. Ricardo Jorge de Portugal, en Lisboa.
El sexto laboratorio de referencia para difteria y tos ferina es un consorcio liderado por la Universidad de Turku, Finlandia, con la participación del Instituto Pasteur de Francia, la Universidad Vrije de Bruselas y el Instituto de Investigación Sciensano que es el Instituto Nacional de Bélgica.
